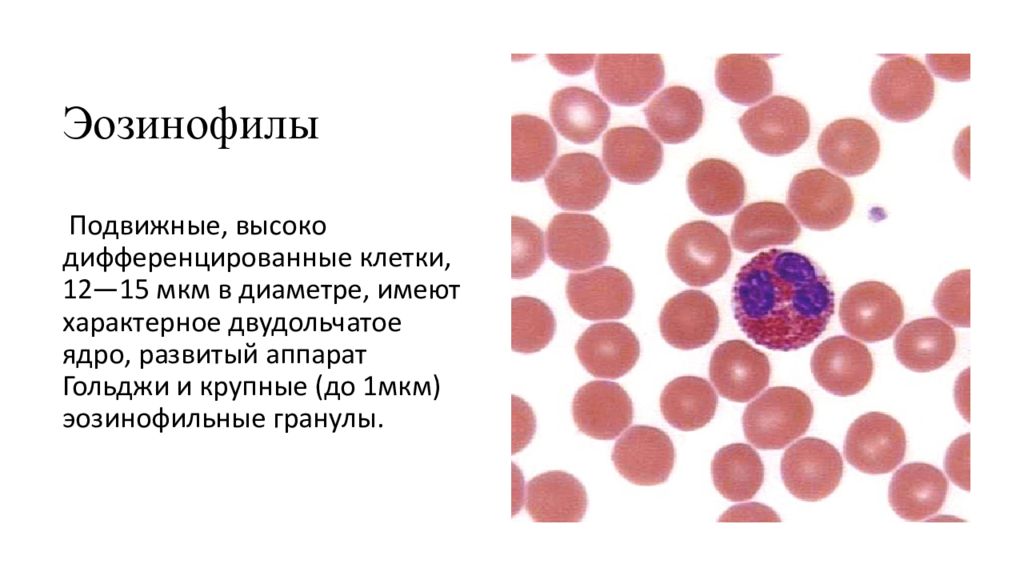

Эозинофилы — тип белых кровяных клеток, играющих ключевую роль в иммунной системе, особенно при аллергических реакциях и паразитарных инфекциях. Повышение их уровня в крови, называемое эозинофилией, может указывать на различные заболевания, требующие внимания. В статье рассмотрим причины повышения эозинофилов у взрослых, сопутствующие симптомы, а также методы диагностики и лечения. Понимание этих аспектов поможет читателям своевременно обратиться за медицинской помощью и предпринять необходимые меры для поддержания здоровья.
Описание эозинофилов
Структурные компоненты крови включают в себя красные и белые клетки, а именно эритроциты и лейкоциты. Эозинофилы представляют собой подгруппу лейкоцитов (1-5% от общего объема), являясь разновидностью клеток иммунной системы. Их впервые выделили в 1846 году, однако полноценное описание появилось только в 1879 году, когда им было дано название, которое сохранилось до наших дней.
Интересный факт!
Немецкий иммунолог, проводя окрашивание мазка крови различными красителями, заметил, что 5% клеток приобрели яркий розовый оттенок. Именно это и стало причиной их названия — эозинофилы, в честь богини утренней зари, Эос. Также краситель, использованный для окраски, получил название в честь этого мифологического персонажа — эозин.
Одной из характерных черт эозинофилов, позволяющей выделить их в отдельный вид лейкоцитов, является двудольчатое ядро. Как и другие форменные элементы крови, они образуются в костном мозге — стволовые клетки под воздействием макрофагов и Т-клеток тимуса. После этого эозинофилы созревают в течение 3-4 дней, а затем циркулируют в кровотоке около 12 часов, распределяясь по всем органам и системам. Наибольшее их количество наблюдается в тканях органов дыхательной системы, желудочно-кишечного тракта, а также в слизистых оболочках и коже.
Эти клетки достаточно крупные и обладают способностью к хемотаксису, что означает, что они могут «осознанно» перемещаться в тканях и жидкостях организма, выбирая направление своего движения. Кроме того, эозинофилы не только выявляют чуждые организму агенты, но и способны захватывать их (независимо от их агрегатного состояния), переваривать и уничтожать. На поверхности этих клеток расположено множество рецепторов, которые активируются комплементом (сывороточным белком), иммуноглобулинами (IgG, IgE) и гистамином (биологически активным веществом).

Повышенные эозинофилы в крови у взрослых могут свидетельствовать о различных заболеваниях и состояниях. Врачи отмечают, что основными причинами являются аллергические реакции, паразитарные инфекции и некоторые аутоиммунные заболевания. Эозинофилия может также возникать при хронических воспалительных процессах, таких как бронхиальная астма или экзема. Для диагностики важно провести комплексное обследование, включая анализы крови и, при необходимости, дополнительные исследования.
Лечение зависит от основной причины повышения уровня эозинофилов. В случае аллергий назначаются антигистаминные препараты и кортикостероиды, а при паразитарных инфекциях — антипаразитарные средства. Важно также учитывать общее состояние пациента и сопутствующие заболевания. Врачи подчеркивают, что своевременная диагностика и правильное лечение могут значительно улучшить качество жизни и предотвратить осложнения.
Функции эозинофилов
Иммунная система играет ключевую роль в поддержании нормального функционирования организма. Она способна распознавать чуждые организму агенты и патогены, оценивать их потенциальную угрозу и, в конечном итоге, уничтожать их.
Повышенный уровень эозинофилов может указывать на наличие опасности. Эти клетки с двудольными ядрами попадают в кровоток, выявляют воспалительные процессы, проникают в их очаги и активируют рецепторы других лейкоцитов. В результате совместными усилиями они уничтожают вирусы и аллергены, а также подавляют жизнедеятельность паразитов на всех этапах.
Эозинофилы помечают чуждые вещества и разрушают клеточные структуры, окружающие места их локализации. Некоторые из них формируют мембранные капсулы, что облегчает процесс выведения.
Таким образом, эозинофилы не только выявляют и нейтрализуют угрозы, но и регулируют воспалительные реакции, подавляя очаги воспаления. Они замедляют распространение инфекций или паразитов и помогают купировать аллергические реакции на начальных стадиях.
| Причина повышенных эозинофилов (эозинофилия) | Механизм повышения | Лечение и рекомендации |
|---|---|---|
| Аллергические реакции (астма, аллергический ринит, атопический дерматит, пищевая аллергия, лекарственная аллергия) | Высвобождение гистамина и других медиаторов воспаления, привлекающих эозинофилы к месту аллергической реакции. | Исключение контакта с аллергеном, антигистаминные препараты, кортикостероиды (местные или системные), специфическая иммунотерапия (при необходимости). |
| Паразитарные инвазии (гельминтозы: аскаридоз, токсокароз, трихинеллез, шистосомоз и др.) | Эозинофилы участвуют в защите организма от паразитов, выделяя токсичные вещества, разрушающие их. | Антигельминтные препараты (в зависимости от вида паразита), симптоматическое лечение. |
| Аутоиммунные заболевания (эозинофильный эзофагит, эозинофильный гастроэнтерит, системная красная волчанка, ревматоидный артрит) | Нарушение иммунной регуляции приводит к атаке собственных тканей организма, в которой могут участвовать эозинофилы. | Иммуносупрессивные препараты, кортикостероиды, биологическая терапия, симптоматическое лечение. |
| Опухолевые заболевания (лимфомы, лейкозы, некоторые солидные опухоли) | Некоторые опухоли могут продуцировать цитокины, стимулирующие выработку и активацию эозинофилов. | Химиотерапия, лучевая терапия, хирургическое удаление опухоли, таргетная терапия. |
| Лекарственная реакция (например, на антибиотики, НПВС, некоторые противосудорожные препараты) | Иммунная система реагирует на лекарственное вещество как на чужеродный агент, вызывая эозинофильную реакцию. | Отмена препарата, вызвавшего реакцию, симптоматическое лечение (антигистаминные, кортикостероиды). |
| Эозинофильные синдромы (гиперэозинофильный синдром) | Редкие состояния, характеризующиеся стойким и значительным повышением эозинофилов без явной причины, приводящие к поражению органов. | Кортикостероиды, иммуносупрессивные препараты, таргетная терапия (например, ингибиторы тирозинкиназы при определенных мутациях). |
| Другие причины (некоторые инфекции, заболевания надпочечников, облучение) | Разнообразные механизмы, влияющие на продукцию и миграцию эозинофилов. | Лечение основного заболевания, симптоматическая терапия. |
Норма эозинофилов
У взрослых нормальные показатели эозинофилов составляют от 1 до 5% от общего числа лейкоцитов, что соответствует 0,02-0,310^9/л. Этот уровень не зависит от возраста. Показатель, превышающий 0,410^9/л, считается повышенным, при этом наблюдаются суточные колебания. Увеличение количества лейкоцитов с двудольными ядрами обозначается как эозинофилия.
При интерпретации результатов анализов важно учитывать влияние различных факторов:
- Время суток. Уровень эозинофилов может увеличиваться на 30% вечером, достигая 40% в промежутке с 12 до 2 часов ночи.
- Некоторые заболевания, такие как туберкулез или острые инфекционные процессы, могут оказывать влияние на этот показатель.
- Применение определенных медикаментов, включая антибиотики, спазмолитики, бета-блокаторы, сульфаниламиды, а также препараты, содержащие йод или хинин, такие как эуфиллин.
- Чрезмерное употребление сладостей или алкоголя.
Обратите внимание!
Для определения уровня эозинофилов обычно берут анализ крови из пальца (реже из вены), а также проводят мазок — соскоб эпителия из носовой полости. Второй метод исследования менее информативен.
Эозинофилия делится на несколько степеней:
- Легкая — содержание 400-1500*10^9/л (до 10%);
- Средняя — 1500-5000*10^9/л (до 15%);
- Тяжелая — превышает 5000*10^9/л (более 15%);
По верхней границе этого показателя можно оценить состояние иммунной системы. Резкое увеличение уровня эозинофилов может происходить на фоне острых состояний, таких как гнойно-воспалительные процессы, инфекционные заболевания, заражение паразитами или выброс гистамина при аллергических реакциях.
Эозинофилы могут быть понижены как у взрослых, так и у детей: причины и лечение. Эозинофилы — это клетки, относящиеся к лейкоцитам, которые играют важную роль в защите организма. После…
Разница показателей у женщин и мужчин
В нормальных условиях различий по половому признаку не наблюдается. Однако в зависимости от фазы менструального цикла уровень показателя варьируется. В начале цикла, когда происходит отторжение эндометрия матки, он увеличивается, а во время овуляции — снижается. У мужчин на количество эозинофилов могут оказывать влияние длительные и интенсивные физические нагрузки.
При беременности
В первом триместре наблюдается снижение объема крупных двухъядерных лейкоцитов, который может достигать нуля. В этот период формируется третий круг кровообращения — плацентарный, который необходим для доставки питательных веществ к развивающемуся плоду. Увеличивается объем плазмы, что приводит к ее разжижению и, соответственно, к уменьшению количества всех форменных элементов крови.
Во втором и третьем триместрах уровень эозинофилов восстанавливается до нормальных значений. Небольшие колебания могут возникать в ответ на аллергены — в это время организм может реагировать даже на вещества, которые ранее не вызывали реакции. Опытные врачи не рассматривают такие изменения (в пределах единиц) как признак развития или обострения заболеваний. Рекомендуется повторная сдача анализов через 7-10 дней.
Снижение уровня эозинофилов во втором и третьем триместрах может указывать на:
- наличие заболеваний;
- кровотечения;
- истощение и длительное нервное напряжение, что часто приводит к плохому сну у беременных, особенно перед родами;
- прием медикаментов, способствующих аллергическим реакциям.
Постоянно низкий уровень эозинофилов во время беременности может свидетельствовать о снижении иммунной активности, что нежелательно, так как отсутствие реакции на чуждые агенты может привести к проникновению инфекций или токсинов через плацентарный барьер. Особенно опасны глистные инвазии. Повышенные показатели, подтвержденные несколькими анализами, могут указывать на те же проблемы, что и в обычном состоянии — заболевания, аллергии, органические патологии.
Причины повышения
Важно разобраться, почему произошли изменения в показателях у взрослого человека, выявленные при многократной сдаче анализов. Это может быть признаком развития заболеваний или инфекций. Если изменения незначительные, то они могут не вызывать никаких симптомов.
В более серьезных случаях рекомендуется провести углубленный анализ крови, основываясь на жалобах пациента. Необходимо выяснить причины повышения уровня эозинофилов у взрослого. К самостоятельным заболеваниям, которые могут вызывать это состояние, относятся пневмония, васкулиты, гранулематозы и тропическая эозинофилия. Остальные состояния и болезни, приводящие к изменениям, можно классифицировать на несколько групп.
Гельминты и паразиты
Увеличение количества форменных элементов, таких как двухъядерные клетки, происходит при заражении различными паразитами, включая аскарид, лямблий, токсокар и эхинококков. Этот рост наблюдается на всех этапах жизненного цикла паразитов — во время их миграции, развития и достижения зрелости, а также в период активной жизнедеятельности. Пока организм не избавится от токсинов, образующихся в результате распада паразитов, уровень показателя не вернется к норме.
Причины снижения уровня эозинофилов в крови. Кроветворная система человека функционирует в костном мозге и производит пять типов лейкоцитов, среди которых находятся и эозинофилы.

Заболевания ЖКТ
В данном случае могут быть выявлены такие заболевания, как гастриты, язвенная болезнь, серьезные заболевания печени, гастроэнтерит, болезнь Крона и подобные. На основе анализа крови и жалоб пациентов диагноз не устанавливается. Требуются дополнительные исследования — как лабораторные, так и инструментальные, например, ФГС, УЗИ и другие.

Атопические процессы
Наиболее распространенные причины увеличения уровня эозинофилов в крови у взрослых связаны с заболеваниями, которые свидетельствуют о предрасположенности к аллергическим реакциям. Механизмы этих процессов до сих пор не полностью изучены, однако основным триггером выступает гиперчувствительность немедленного типа.
Обратите внимание!
Симптомы могут проявляться как временно, так и постоянно, а также рецидивировать под воздействием внешних факторов.
В эту категорию входят:
- бронхиальная астма и хроническое воспаление бронхов;
- сенная лихорадка и аллергический ринит;
- атопическая экзема.
Также сюда относится риноконъюнктивит и реакции на различные запахи, а также контакт с аллергенами. Увеличение уровня эозинофилов может быть вызвано аллергиями накопительного характера, например, в результате длительного применения медикаментов.
Заболевания крови
К данной категории относятся лейкозы, расстройства усвоения витаминов группы В, мегабластная анемия (болезнь Аддисона-Бирмера) и нарушения в работе кроветворной системы. В общем, сюда включены все заболевания, которые приводят к изменению пропорций клеточных компонентов крови.
Инфекции
Это самая большая категория. Под данным термином понимаются острые инфекции — ОРВИ, грипп, сезонные простуды, туберкулез, сифилис, СПИД и ВИЧ. По последним данным исследований, инфекция также играет роль в возникновении ревматоидных процессов, артритов и артрозов — заболеваний костной ткани, а также легочных заболеваний. Это означает, что при их развитии также наблюдается увеличение числа лейкоцитов с двудольным ядром.
Можно ли описать симптомы эозинофилии
Поскольку данное заболевание не является самостоятельным, а возникает на фоне других патологий как результат неблагоприятных изменений, специфические признаки отсутствуют. Основные симптомы обусловлены первичными заболеваниями. Для диагностики врач рекомендует пройти расширенный анализ крови, принимая во внимание жалобы пациента.
Например, к симптомам глистных инвазий и паразитарных инфекций можно отнести резкое снижение веса, бледность кожи, субфебрильную температуру, общую слабость, потерю аппетита, а также боли в мышцах и суставах, сухой кашель. Паразиты выделяют токсины, что приводит к общей интоксикации организма. У взрослых для значительного ухудшения состояния требуется продолжительное время, и характерные симптомы могут отсутствовать. Похожая клиническая картина наблюдается при заболеваниях сердечно-сосудистой системы или онкологических процессах.
Аллергические реакции могут проявляться в виде сыпи (крапивницы), волдырей, а также снижением температуры и артериального давления, коллапсом и шоком. Симптомы, связанные с заболеваниями желудочно-кишечного тракта, включают тошноту, интоксикацию, рвоту, диспепсию, а также усиленный или ослабленный метеоризм и наличие крови в кале.
При поражениях дыхательной системы в легких могут образовываться инфильтраты, однако внешние проявления будут незначительными. К ним относятся кашель, периодические повышения температуры, слабость и снижение работоспособности.
Эозинофильные инфильтраты могут возникать в крупных мышцах, причем наиболее опасной зоной является миокард. Новообразования могут привести к сердечной недостаточности, так как объем полостей сердца уменьшается. Это нарушает кровообращение, и органам не хватает кислорода, что увеличивает риск развития инфаркта и инсульта.

Диагностика
При поступлении в стационар осуществляется экспресс-диагностика, которая позволяет определить уровень гемоглобина (наличие или отсутствие анемии), количество лейкоцитов (по этому показателю можно оценить необходимость хирургического вмешательства) и СОЭ — скорость оседания эритроцитов (это индикатор воспалительных процессов). Для определения уровня эозинофилов требуется другой анализ — развернутый, который показывает процентное соотношение форменных элементов крови.
Такой анализ рекомендуется проводить при оценке жалоб пациентов для более точной диагностики. Однако сразу установить диагноз бывает сложно — это лишь начало обследования. Для того чтобы точно выяснить причины эозинофилии, необходимо:
- сдать анализ мочи;
- провести биохимическое исследование крови;
- для подтверждения наличия глистных инвазий — исследовать кал или сделать мазок;
- для проверки функций дыхательной системы — пройти рентген, флюорографию или бронхоскопию;
- для диагностики заболеваний желудочно-кишечного тракта — выполнить ФГС.
В дальнейшем могут потребоваться такие исследования, как КТ, МРТ, биопсия, пункция суставов, а также проверки работы печени и почек, исследования сердца и сосудов. Объем необходимых обследований зависит от состояния пациента и возможности постановки диагноза. Например, при аллергических реакциях с характерными симптомами пациента направляют в лабораторию для выявления аллергена. Многочисленные обследования, многие из которых могут вызывать дискомфорт, не проводятся без необходимости.
Лечение
Снизить уровень эозинофилов без устранения причины, вызывающей его повышение, невозможно. Эозинофилия легкой степени (400-1500*10^9/л) является достаточным основанием для обращения к врачу. В дальнейшем могут потребоваться различные меры: диагностика, медикаментозное лечение, хирургическое вмешательство, коррекция образа жизни и изменения в питании. Например, переход на щадящую диету является одним из ключевых методов лечения заболеваний желудочно-кишечного тракта, а исключение определенных продуктов из рациона может помочь при аллергических реакциях. При выздоровлении уровень эозинофилов снижается.
Важно!
Развернутый анализ следует сдавать 2-3 раза. Как уже упоминалось, на уровень эозинофилов могут влиять внешние факторы, время суток и особенности питания.
Чтобы предотвратить развитие эозинофилии, необходимо обращаться к врачу при появлении симптомов ухудшения здоровья. Специальные профилактические меры не разработаны.
Опасно не только повышение уровня эозинофилов у взрослых, но и их снижение, известное как эозинопения. Это состояние свидетельствует о значительном ослаблении иммунной системы, острых кишечных инфекциях (таких как брюшной тиф и дизентерия), остром аппендиците, сепсисе, инфаркте миокарда, ожогах и травмах. При выздоровлении уровень эозинофилов резко возрастает, а затем остается стабильным в течение примерно двух месяцев. Однако в этом случае лечение не требуется, и состояние восстанавливается самостоятельно.
Профилактика повышения эозинофилов
Профилактика повышения уровня эозинофилов в крови у взрослых включает в себя комплекс мер, направленных на снижение риска развития заболеваний, которые могут привести к этому состоянию. Эозинофилы — это тип белых кровяных клеток, которые играют важную роль в иммунной системе, особенно в борьбе с аллергическими реакциями и паразитарными инфекциями. Повышение их уровня может свидетельствовать о наличии различных заболеваний, поэтому важно принимать меры для предотвращения их повышения.
Одним из ключевых аспектов профилактики является поддержание здорового образа жизни. Это включает в себя сбалансированное питание, регулярные физические нагрузки и достаточный уровень сна. Правильное питание, богатое витаминами и минералами, способствует укреплению иммунной системы и снижению риска аллергий и инфекций. Рекомендуется включать в рацион больше фруктов, овощей, цельнозерновых продуктов и нежирных белков.
Также важно избегать контакта с известными аллергенами. Если у человека есть предрасположенность к аллергическим реакциям, необходимо выявить и минимизировать воздействие аллергенов, таких как пыльца, шерсть животных, пыль и определенные продукты питания. Для этого может потребоваться консультация аллерголога, который поможет определить индивидуальные триггеры и предложит соответствующие меры предосторожности.
Регулярные медицинские осмотры и анализы крови также играют важную роль в профилактике. Это позволяет своевременно выявлять изменения в уровне эозинофилов и другие отклонения в состоянии здоровья. При наличии хронических заболеваний, таких как астма или аллергический ринит, важно следовать рекомендациям врача и принимать назначенные препараты для контроля симптомов и предотвращения обострений.
Кроме того, следует уделять внимание психоэмоциональному состоянию. Стресс может негативно влиять на иммунную систему и способствовать развитию различных заболеваний. Практики релаксации, такие как йога, медитация и дыхательные упражнения, могут помочь снизить уровень стресса и улучшить общее состояние здоровья.
В заключение, профилактика повышения уровня эозинофилов в крови требует комплексного подхода, включающего здоровый образ жизни, избегание аллергенов, регулярные медицинские осмотры и управление стрессом. Эти меры помогут не только снизить риск повышения эозинофилов, но и улучшить общее состояние здоровья и качество жизни.
Прогноз и возможные осложнения
Повышенные уровни эозинофилов в крови, известные как эозинофилия, могут указывать на различные заболевания и состояния, которые требуют внимательного наблюдения и лечения. Прогноз для пациента зависит от основного заболевания, вызвавшего увеличение эозинофилов, а также от своевременности и адекватности проведенной терапии.
В большинстве случаев, если эозинофилия является следствием аллергической реакции или инфекционного процесса, прогноз может быть благоприятным. После устранения причины, уровень эозинофилов обычно возвращается к норме, и симптомы, связанные с заболеванием, исчезают. Например, при аллергическом рините или астме, адекватное лечение может значительно улучшить состояние пациента и снизить уровень эозинофилов.
Однако в некоторых случаях эозинофилия может быть признаком более серьезных заболеваний, таких как аутоиммунные расстройства, некоторые виды рака или инфекционные болезни, требующие длительного и сложного лечения. В таких ситуациях прогноз может быть менее оптимистичным, особенно если заболевание было запущено или диагностировано на поздних стадиях. Например, при эозинофильной гранулематозе с полиангиитом (синдром Чург-Стросса) или эозинофильной лейкемии, лечение может быть сложным и требовать комплексного подхода, включая химиотерапию или иммуносупрессивные препараты.
Что касается возможных осложнений, то они могут варьироваться в зависимости от основного заболевания. У пациентов с тяжелой эозинофилией могут развиваться такие осложнения, как повреждение органов (например, легких, сердца или почек), что может привести к серьезным последствиям для здоровья. Эозинофилы могут накапливаться в тканях, вызывая воспаление и повреждение, что в свою очередь может привести к функциональным нарушениям органов.
Кроме того, при наличии хронической эозинофилии существует риск развития вторичных инфекций, так как иммунная система может быть ослаблена. Это особенно актуально для пациентов с аутоиммунными заболеваниями или теми, кто получает иммуносупрессивную терапию.
Таким образом, важно не только выявить причину повышения уровня эозинофилов, но и тщательно следить за состоянием пациента, чтобы предотвратить возможные осложнения и обеспечить своевременное лечение. Регулярные обследования и контроль уровня эозинофилов в крови помогут врачам оценить эффективность терапии и при необходимости скорректировать лечение.
Рекомендации по образу жизни и питанию
При повышении уровня эозинофилов в крови важно не только следовать рекомендациям врача и принимать назначенные препараты, но и внести изменения в образ жизни и рацион питания. Это поможет улучшить общее состояние организма и снизить уровень воспалительных процессов.
1. Избегайте аллергенов. Если повышенные эозинофилы связаны с аллергическими реакциями, необходимо выявить и исключить контакт с аллергенами. Это могут быть пыльца растений, домашние животные, пыль, определенные продукты питания и химические вещества. Ведение дневника питания и симптомов может помочь в определении триггеров.
2. Поддерживайте чистоту в доме. Регулярная уборка и проветривание помещений помогут снизить уровень аллергенов в воздухе. Используйте пылесосы с HEPA-фильтрами и мойте полы, чтобы уменьшить количество пыли и аллергенов.
3. Правильное питание. Включите в рацион продукты, богатые антиоксидантами, такие как фрукты и овощи. Они помогают укрепить иммунную систему и снизить воспаление. Особенно полезны такие продукты, как ягоды, цитрусовые, брокколи и шпинат. Избегайте продуктов, которые могут вызывать аллергические реакции, таких как молочные продукты, орехи, морепродукты и глютен, если у вас есть на них непереносимость.
4. Увлажнение. Пить достаточное количество воды важно для поддержания нормального функционирования организма. Вода помогает выводить токсины и поддерживает здоровье кожи, что может быть особенно важно при аллергических реакциях.
5. Физическая активность. Регулярные физические нагрузки способствуют улучшению кровообращения и укреплению иммунной системы. Умеренные аэробные упражнения, такие как ходьба, плавание или йога, могут помочь снизить уровень стресса и улучшить общее состояние здоровья.
6. Управление стрессом. Стресс может усугубить аллергические реакции и воспалительные процессы. Практики релаксации, такие как медитация, глубокое дыхание и занятия хобби, помогут снизить уровень стресса и улучшить общее самочувствие.
7. Регулярные медицинские осмотры. Важно проходить регулярные медицинские обследования и следить за уровнем эозинофилов в крови. Это поможет вовремя выявить изменения и скорректировать лечение при необходимости.
Следуя этим рекомендациям, можно значительно улучшить качество жизни и снизить уровень эозинофилов в крови. Однако важно помнить, что любые изменения в образе жизни и питании должны обсуждаться с врачом, чтобы избежать негативных последствий для здоровья.